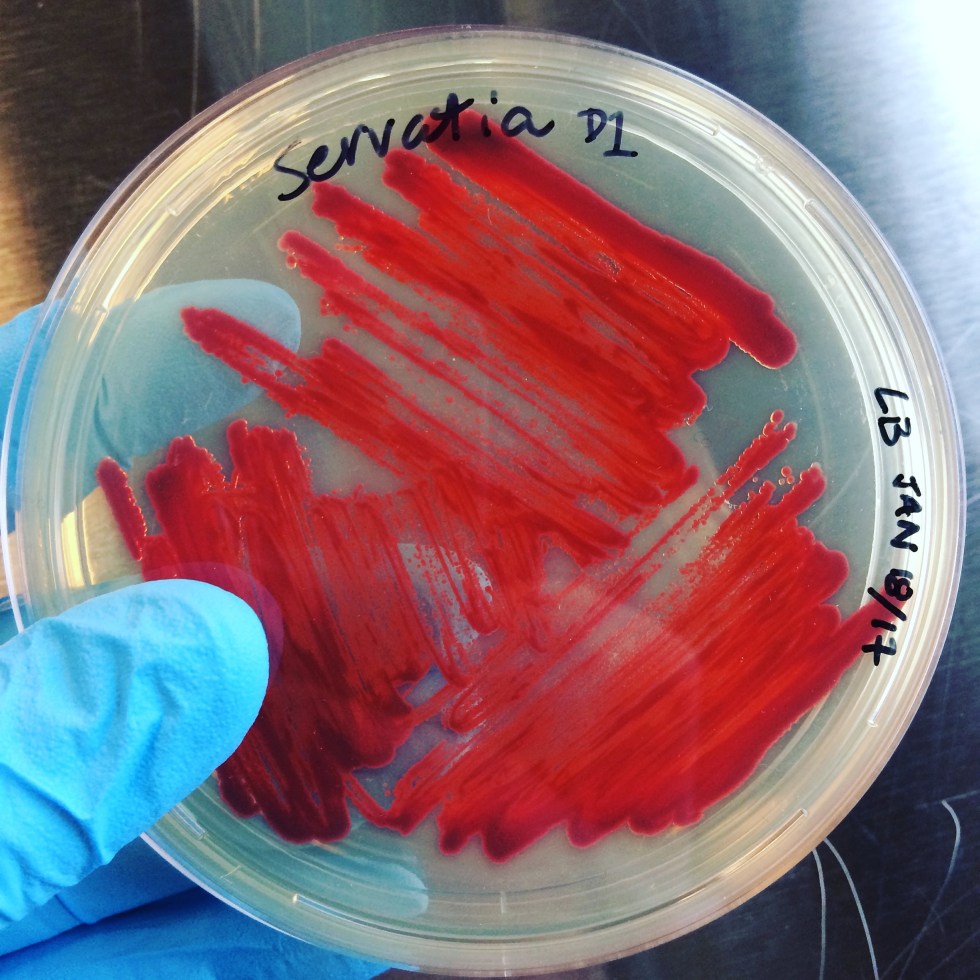

Category: professional development


HALFWAY TO THE FUTURE SYMPOSIUM (HttF), SANTA CRUZ, US

Eighteenth International Conference on the Arts in Society, Kraków, Poland

The Arts in Society conference, Zaragota, ES

AAANZ IMPACT Conference, Sydney, AU

FULL: Bioart Coven online course at School of Machines, Making and Make Believe, Berlin/ online

UNLOCK: GENDERED EXPERIENCES OF TECHNOLOGY with Cornelia Sollfrank

Earth Observatory Array Activation – Shift Register (Montreal)